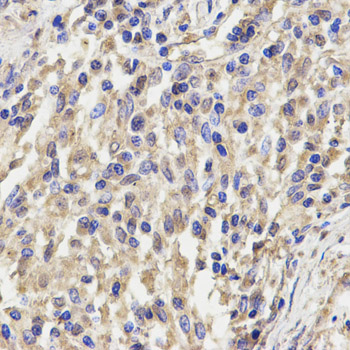
A2039: image 2

For quotations, please use our online quotation form, and you may also contact us by
sales@neoscientific.com
+1-888.733.6849
+1-617.299.7367 (Int’l)
+1-888.733.6849
+1-617.299.7367 (Int’l)
| Reactivity | Human Mouse |
| Tested applications | WB IHC IF |
| Recommended Dilution | WB 1:500 - 1:2000 IHC 1:50 - 1:200 IF 1:50 - 1:200 |
| Calculated MW | 20kDa |
| Observed MW | Refer to Figures |
| Immunogen | Recombinant protein of human KLRD1 |
| Storage Buffer | Store at -20℃. Avoid freeze / thaw cycles. Buffer: PBS with 0.02% sodium azide, 50% glycerol, pH7.3. |
| Synonym | CD94; KLRD1; |

Western blot analysis of extracts of K562 cell lines, using KLRD1 antibody.
Immunohistochemistry of paraffin-embedded human lung cancer using KLRD1 antibody at dilution of 1:200 (x400 lens)

Immunohistochemistry of paraffin-embedded mouse lung cancer using KLRD1 antibody at dilution of 1:200 (x400 lens)

Immunofluorescence analysis of MCF7 cell using KLRD1 antibody. Blue: DAPI for nuclear staining.
Natural killer (NK) cells are a distinct lineage of lymphocytes that mediate cytotoxic activity and secrete cytokines upon immune stimulation. Several genes of the C-type lectin superfamily, including members of the NKG2 family, are expressed by NK cells and may be involved in the regulation of NK cell function. KLRD1 (CD94) is an antigen preferentially expressed on NK cells and is classified as a type II membrane protein because it has an external C terminus. Three transcript variants encoding two different isoforms have been found for this gene. [provided by RefSeq, Jul 2008]
N/A